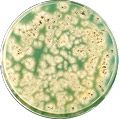
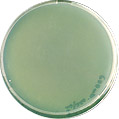
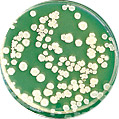

表面殺菌装置
ステリアイS
高出力表面殺菌装置 SHG
小型で強力、安定した紫外線パワーを発揮します。
短時間で包材や食品などの表面殺菌ができるパワフルな紫外線殺菌装置です。
従来の硬質ガラス製低出力殺菌灯に比べ、数十倍(当社比)の殺菌能力をもち、黒カビや耐性の強い菌も数十秒で死滅させることができます。
特長
ランプ管壁温度を一定に保つ水冷方式採用

(ランプ全面を冷却水が包んでいます。)
- ランプ全面を冷却水で覆う二重管構造。
熱エネルギーは同ワットのランプに比べ1/3以下とクールでむらの無い殺菌線照射が行えます。 - 水冷コントロールシステムが常にランプの最適温度を維持、高い殺菌能力を発揮します。
また出力安定後、周囲温度の影響で殺菌能力が変化することはありません。 - 再点灯の際も瞬時に出力が安定、持続した殺菌効果を保ちます。
コンパクトで均一殺菌、用途に応じたフレキシブル設計
- ランプは200Wと400W、それぞれ1灯用から10灯用まで用途に応じた設計ができます。
- 直管タイプのランプなので、高密度でむら無く照射処理が行えます。
標準仕様としては200W 3灯用、400W 3灯用、400W 5灯用があります。
操作はシンプル、保守管理もスムーズ

- 殺菌ランプの点灯・消灯や水温コントロールは電源装置で一括制御。
万一異常が発生した場合も、警報ブザーが瞬時にお知らせし、安心して運用できます。 - ランプ交換はワンタッチ差込み方式。
また、冷却水は循環方式を採用しているため、メンテナンスも簡単です。
※冷却水(精製水又は純水)は3か月に1回はお取替えください。
調光型安定器搭載(400W殺菌ランプ)
- ワーク停止時のワークへの過剰照射の防止
- 初期過剰UV照射の防止と一定したUV照度での運転により品質安定。(1000時間でUV維持率80%に低下したら400W切替・点灯し同じレベルでUV照射可能)
- ライン設計ではシャッター不要
- 安全設計、電源電圧変動に強い
※ 停止状態が長い場合シャッターを作動させるかランプをOFFにする
| ランプ電力 | 100W | 200W | 400W |
|---|---|---|---|
| UV照度比 | 40% | 60% | 100% |
| ワーク温度上昇 | 70% | 80% | 100% |
※上記は減光例で100W~400Wで任意調光可能


用途例
食品工業
- 食品包装材・シートの殺菌
- 樹脂容器の殺菌・・・ヨーグルト、バター、マーガリンなど
- 缶類・フタの殺菌・・・缶ビール、粉ミルクなど
- ビン類のキャップ・注ぎ口の殺菌・・・生ビール、生酒、酢など
医薬品関係
- クリーンルーム搬入前の殺菌
- リンゲル液・生理食塩水の殺菌
- 薬用ビンの殺菌
用途・システムに合わせた応用例
キャップ類、シャーレ・容器

1~3灯で照射
ビン類

斜め方向照射
広幅コンベア・大型容器類・包装物・ダンボール箱

5~10灯で照射
大型容器類・包装物・ダンボール類

殺菌トンネルによる全方向照射(上下、左右)
大型容器類・ダンボール類

3灯で広角照射
包材シート・ポリエチレン・セロファン

シート類の殺菌
殺菌線照度分布図(400W 3灯用)


殺菌効果データ
<黒カビ>ミルク缶内面
未照射
120mW・sec/cm² UV照射
<枯草菌>医薬品容器収納用ポリ袋内面
未照射

120mW・sec/cm² UV照射
産業用装置の補助金サポート
紫外線殺菌装置をお得に導入

補助金活用で、お得に設備導入しませんか?
岩崎電気では(株)ナビットと提携し、各種助成金・補助金の申請サポートをいたします。













